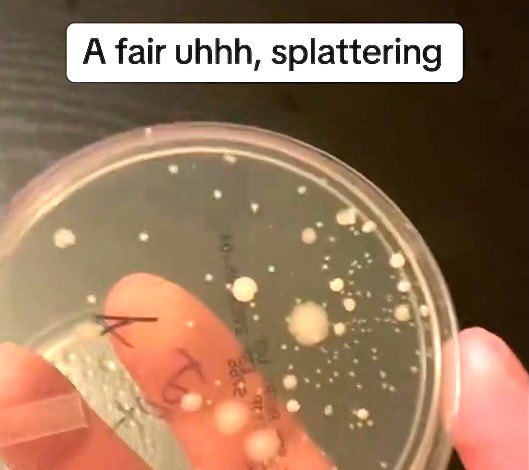
Nick testing his own flatulence for bacteria.

A microbiologist has gone viral after testing his own flatulence for bacteria.
Nick Aicher, who works as a senior quality control analyst, regularly goes viral sharing clips testing the cleanliness of various everyday items with his following of 450,000 on TikTok.
He often takes direction from his band of followers, who request he tests various items to see how much bacteria is lingering on them – including leftover takeaway pizza, petrol pumps, and food dropped on the floor.
READ MORE: Dad hailed ‘genius’ for simple trick that convinces toddler daughter she’s walking the dog
But his recent test is his wackiest yet, after followers dared him to fart and then measure the amount of bacteria it expelled.
Nick begrudgingly obliges and, in the clip, can be seen incubating a sample he claims was taken from his own fart – usually gathered by means of swabbing the area (or, in this case, air) before wiping it on a petri dish.
He then incubates the sample and leaves it to develop before checking for bacterial growth.
The fart had stomach-turning results, with huge blobs of bacteria visible on the dish.
His followers were suitably horrified – though they commended Nick’s scientific efforts.
One person commented: “Ok but was it bare or through clothes? I need to believe there’s a difference.”
“I salute you for actually doing it,” another person wrote.
Someone else added: “Ohhhh oh noooo.”
“A fart is dirty what a surprise,” another viewer commented.
“I thought it would be fun for people to know all the little nastiness that we don’t think about every day,” the Chicago-based content creator told What’s The Jam about why he shares his experiments online.
Nick previously made headlines after putting the ‘five-second rule’ of dropped food to the test, monitoring the bacterial growth on food after it had been on the floor for various time periods.
He found that, whether the food has been on the floor for five seconds or 60, “it’ll be nasty either way” – advising against the practice.
READ MORE: Foodie tries London’s most expensive burger with CAVIAR garnish and whopping £350 price tag